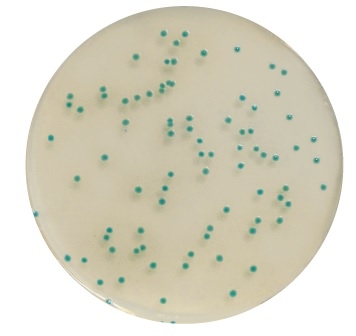
img

CSD Metot

CSD Metot
Crono & Salmo Duo (CSD) senkronize zenginleştirme
Crono & Salmo Duo (CSD), insani tüketim amaçlı gıdalarda (özellikle süt tozlarında, probiyotikli / probiyotiksiz bebek tahıllarında) ve üretim ortamlarına ait çevresel örneklerde Salmonella ve Cronobacter türlerinin eşzamanlı zenginleştirme işlemleri ve tespiti için üretilmiş AFNOR tarafından valide edilmiştir.
CSD metodu ile;
- 50g ağırlığa kadar olan örneklerde negatif sonuç 37 saatte
- 375g ağırlığa kadar olan örneklerde ise negatif sonuç 39 saatte elde edilir.
Güvenilir
ISO 16140-2 validasyon standardı kapsamında, ISO 22964: 2017 standardı referans alınarak BKR 23/12-12/20 referans numarası ile AFNOR tarafından valide edilmiştir.
Basit - Ekonomik
Salmonella spp. ve Cronobacter spp. için eş zamanlı zenginleştirme imkanı sunar.
Kolay - Pratik
Tek bir seçici suplement ile hem Salmonella hem Cronobacter türlerine özgü valide, rapid ve kromojenik tespit yapılabilir. Pratiktir; 1/4 seyretlme ile havuzlama imkanı sağlar.

Ürün Adı: Chromogenic Cronobacter Isolation Agar Base
Ürün Kodu: BK200HA
Miktar: 500g
Ürün Adı: Chromogenic Cronobacter Isolation Agar (CCI) (RTU)
Ürün Kodu: BM15408
Miktar: 20 Petri plates Ø 90 mm
